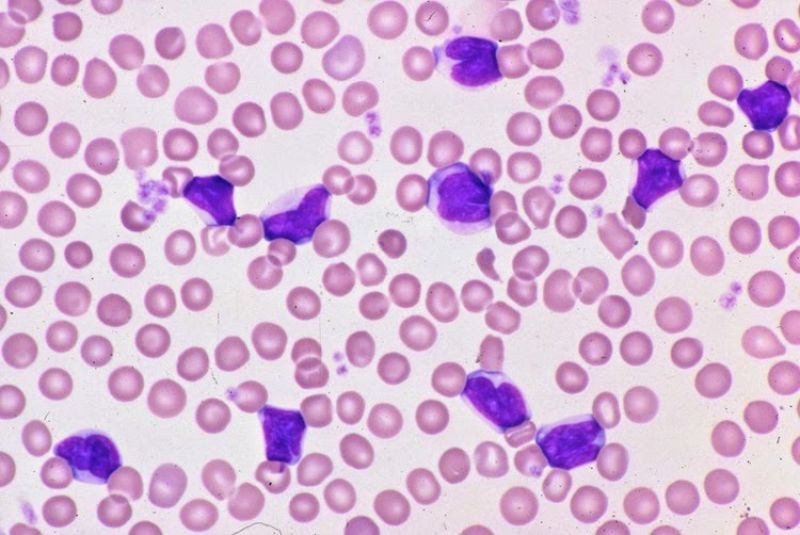
linfocitos-reativos-vs-neoplasicos-principais-diferencas-morfologicas

Aqui você pode estudar
Biomedicina de graça
UM SITE 100% FOCADO NA ÁREA DA BIOMEDICINA, COM CONTEÚDOS GRATUITOS PARA FACILITAR SUA JORNADA. DESTINADO ESPECIALMENTE PARA ESTUDANTES DE BIOMEDICINA.
Linfócitos Reativos vs Neoplásicos: Principais Diferenças Morfológicas
Se você está estudando hematologia ou já começou a rotina em laboratório, provavelmente já se deparou com a dificuldade de…
Plasma e Soro: Quais são as Diferenças?
Se você está começando na área de análises clínicas, provavelmente já se perguntou qual é a real diferença entre plasma…
Relação entre Anemia Falciforme e Malária: Como Funciona?
A relação entre anemia falciforme e malária é um dos exemplos mais clássicos de adaptação evolutiva no corpo humano —…
Alterações Morfológicas das Hemácias: Tipos, Causas e como Identificar no
O que são Alterações Morfológicas das Hemácias?As alterações morfológicas das hemácias fazem parte da rotina de análise em hematologia e…
Melhores Cursos Online de Biomedicina para Horas Complementares
Você está correndo contra o prazo para fechar suas horas complementares, mas não sabe quais cursos realmente valem a pena….
Testes Treponêmicos e Não Treponêmicos: Diferenças, Interpretação e Diagnóstico da
Se você está estudando biomedicina e já se deparou com dúvidas sobre testes treponêmicos e não treponêmicos, saiba que isso…
PRINCIPAIS DISCIPLINAS
Visite nossa Biblioteca
de Biomedicina
Nosso serviço conecta você diretamente à plataformas oficiais. Você escolhe o livro e é redirecionado para comprar NA FONTE, com toda segurança e garantia. Somos o atalho inteligente entre você e sua próxima leitura!
Apenas os melhores livros!
Encontre os melhores livros sem precisar garimpar: já fizemos isso por você
Para estudantes da saúde
Não importa se seu jaleco é branco, azul ou verde. Importa o conhecimento que ele carrega. Nossa biblioteca reúne os livros essenciais para a formação de QUALQUER profissional da saúde